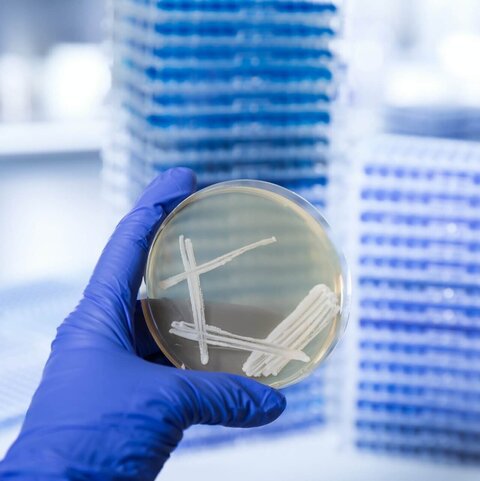
Hand in blue glove holding a petri dish with a Pichia pastoris yeast culture in a biotechnology laboratory, VALIDOGEN

Case Studies from VALIDOGEN
Case Studies – Applications of UNLOCK PICHIA® Technology
This section presents selected case studies that illustrate the application of VALIDOGEN’s UNLOCK PICHIA® technology in recombinant protein expression. The examples cover development of methanol-induced and methanol-free Pichia strains and processes, showing how the platform has been used to meet specific technical and regulatory requirements across different industries.

